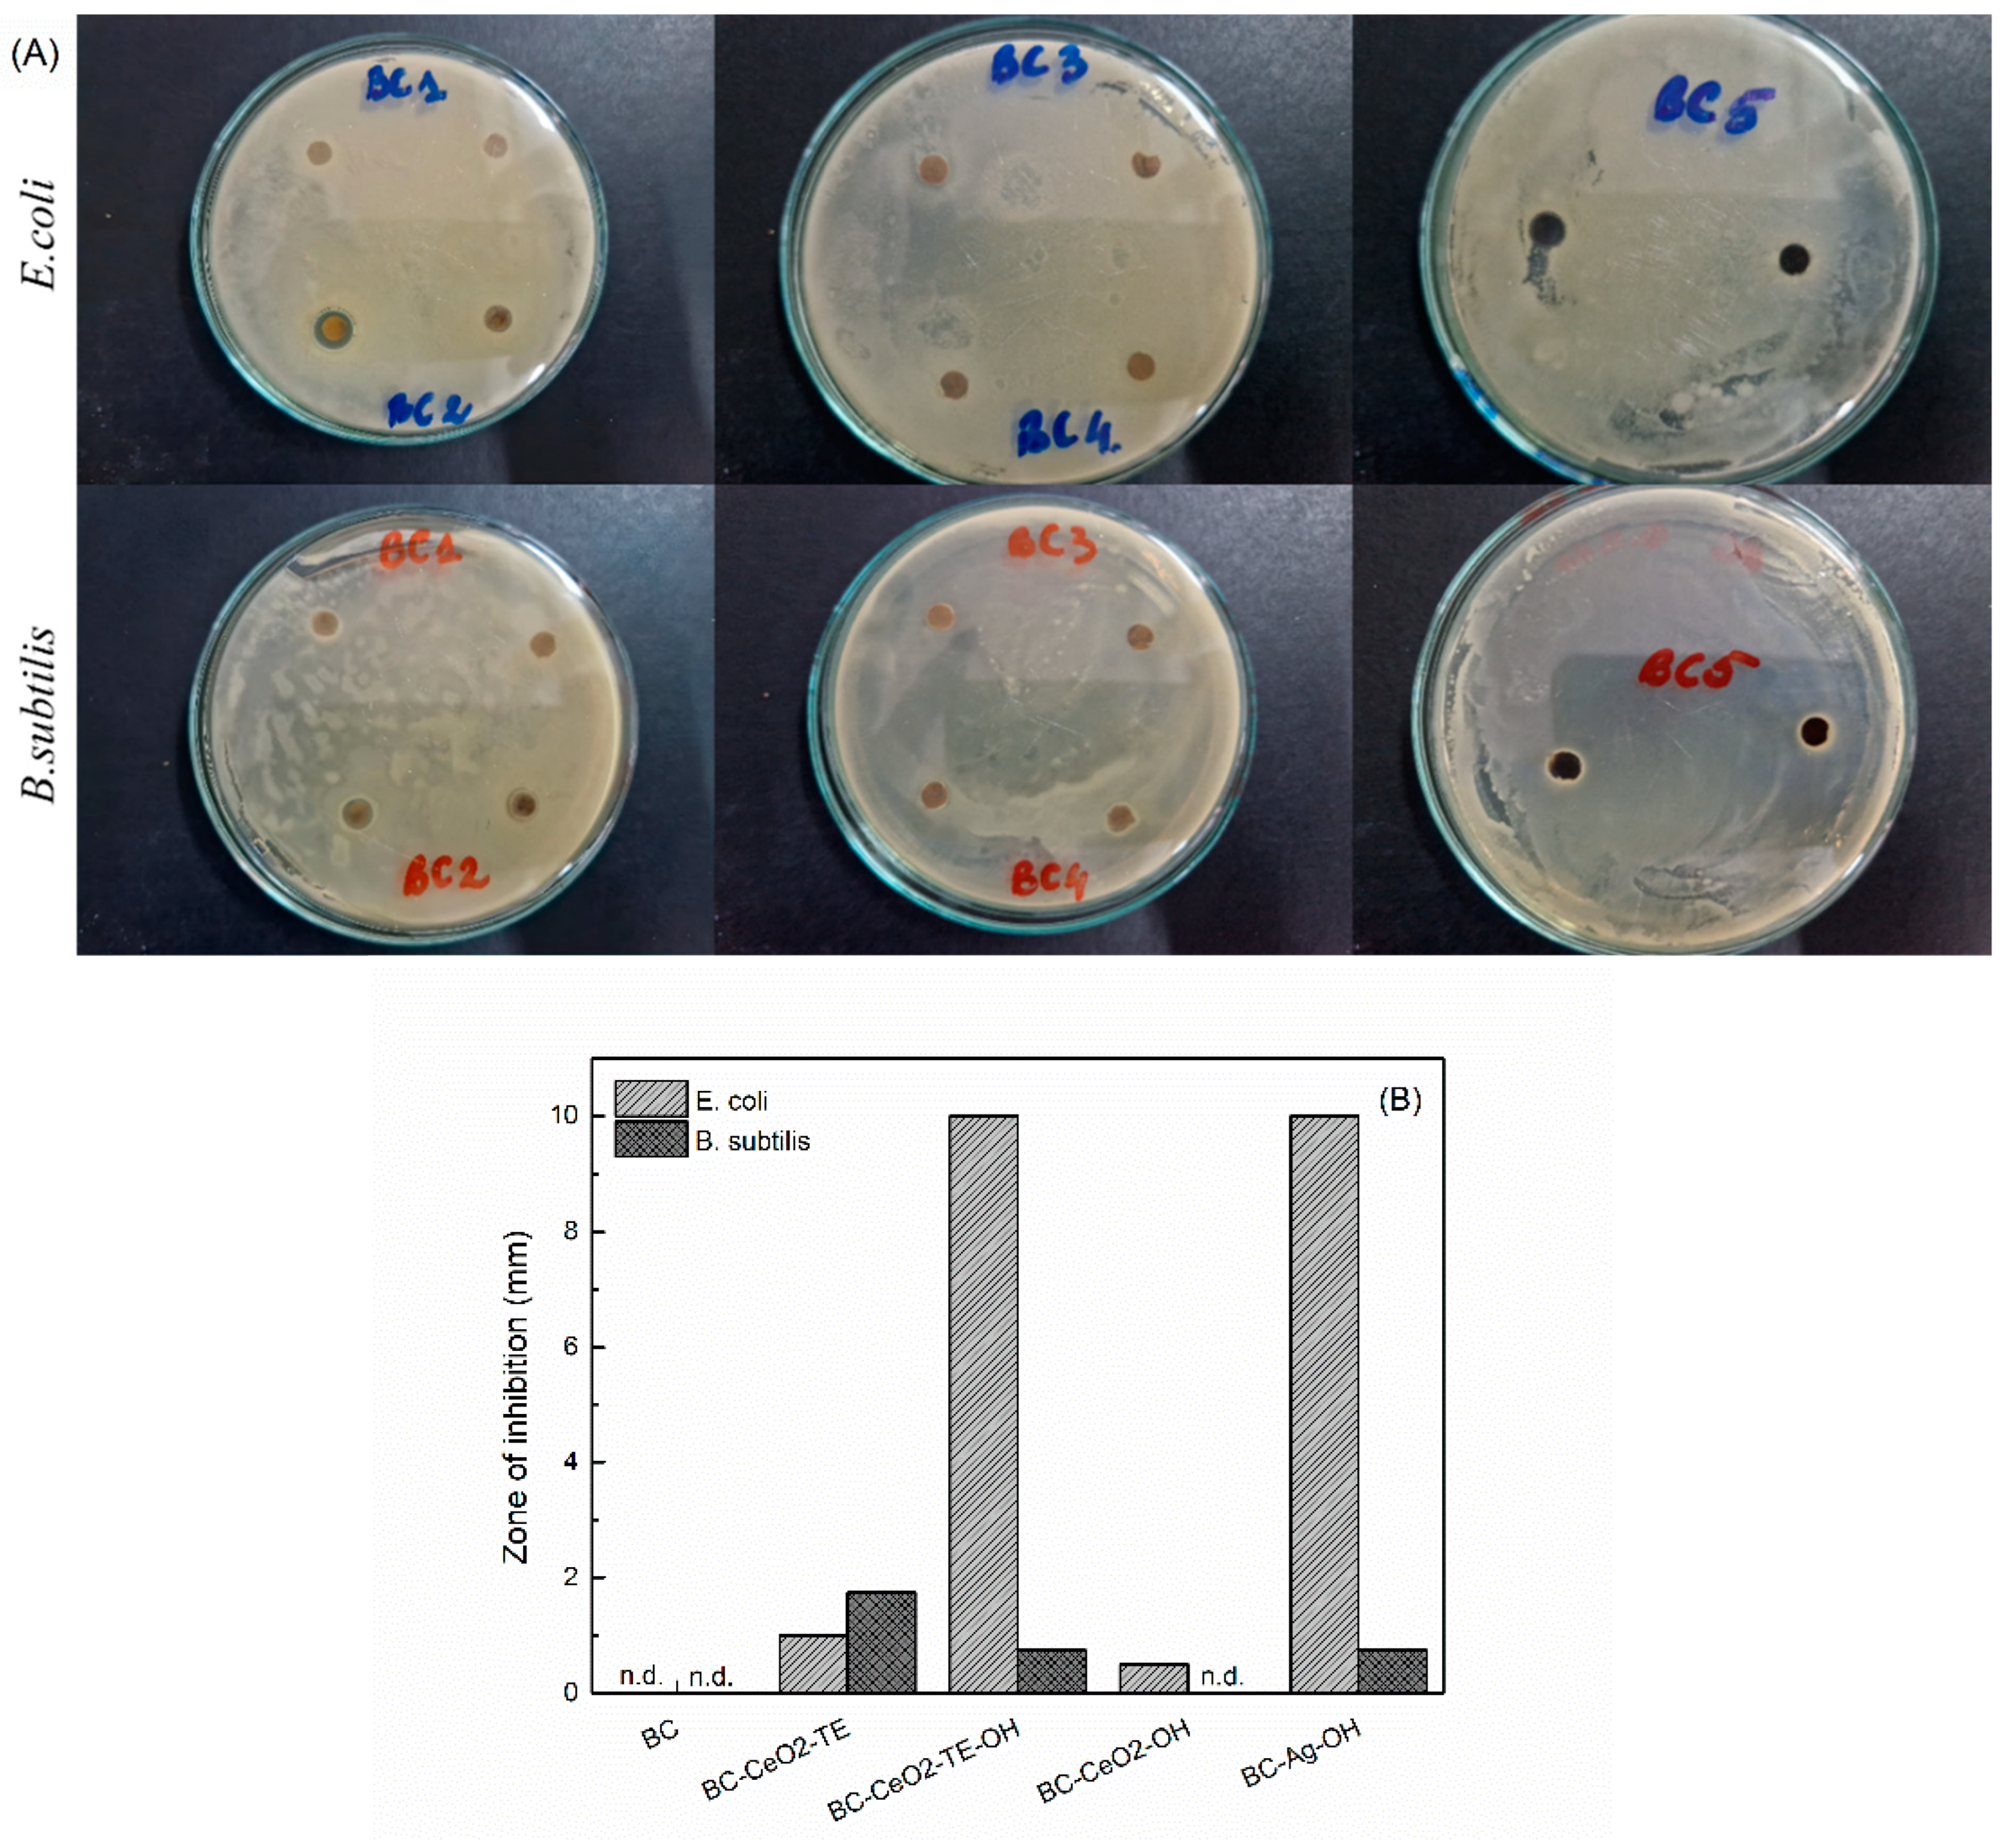
Polymers 17 01225 g009

Bacterial Cellulose-Based Nanocomposites for Wound Healing Applications
Abstract
1. Introduction
2. Materials and Methods
2.1. Materials
2.2. Synthesis of BC Membranes
2.3. Synthesis of Green Precipitating Agent
2.4. Composite Sample Preparation
2.5. Characterization Methods
2.5.1. Thermal Analysis
2.5.2. Fourier-Transform Infrared Spectroscopy
2.5.3. X-Ray Diffraction
2.5.4. Scanning Electron Microscopy
2.5.5. Energy Dispersive X-Ray Spectroscopy
2.5.6. Swelling Tests
2.5.7. Antibacterial Tests
2.5.8. Cell Tests
Direct Contact Method
Extraction Method
2.5.9. Drug Release Profile
3. Results and Discussion
3.1. Material Characterization
3.1.1. Thermal Analysis
3.1.2. EDX Spectroscopy
3.1.3. FTIR Spectroscopy
3.1.4. XRD Analysis
3.1.5. SEM Analysis
3.2. Sorption/Desorption Capability
3.2.1. Swelling Tests
3.2.2. Drug Release
3.3. Biological Characterization
3.3.1. Antibacterial Testing
3.3.2. Cellular Protocols
Direct Contact Method
Extraction Method
4. Conclusions
Supplementary Materials
Author Contributions
Funding
Institutional Review Board Statement
Data Availability Statement
Acknowledgments
Conflicts of Interest
References
- Jeschke, M.G.; Van Baar, M.E.; Choudhry, M.A.; Chung, K.K.; Gibran, N.S.; Logsetty, S. Burn injury. Nat. Rev. Dis. Prim. 2020, 6, 11. [Google Scholar] [CrossRef] [PubMed]
- Markiewicz-Gospodarek, A.; Kozioł, M.; Tobiasz, M.; Baj, J.; Radzikowska-Büchner, E.; Przekora, A. Burn Wound Healing: Clinical Complications, Medical Care, Treatment, and Dressing Types: The Current State of Knowledge for Clinical Practice. Int. J. Environ. Res. Public Health 2022, 19, 1338. [Google Scholar] [CrossRef] [PubMed]
- Żwierełło, W.; Piorun, K.; Skórka-Majewicz, M.; Maruszewska, A.; Antoniewski, J.; Gutowska, I. Burns: Classification, Pathophysiology, and Treatment: A Review. Int. J. Mol. Sci. 2023, 24, 3749. [Google Scholar] [CrossRef] [PubMed]
- Pasaribu, K.M.; Ilyas, S.; Tamrin, T.; Radecka, I.; Swingler, S.; Gupta, A.; Stamboulis, A.G.; Gea, S. Bioactive bacterial cellulose wound dressings for burns with collagen in-situ and chitosan ex-situ impregnation. Int. J. Biol. Macromol. 2023, 230, 123118. [Google Scholar] [CrossRef]
- Ghomi, E.R.; Khalili, S.; Khorasani, S.N.; Neisiany, R.E.; Ramakrishna, S. Wound dressings: Current advances and future directions. J. Appl. Polym. Sci. 2019, 136, 47738. [Google Scholar] [CrossRef]
- Yadav, A.; Ujjwal, R.R.; Tripathi, S.; Krishna, S.S. Polymer-based Nanotherapeutics for Burn Wounds. Curr. Pharm. Biotechnol. 2022, 23, 1460–1482. [Google Scholar] [CrossRef]
- Kucińska-Lipka, J.; Gubanska, I.; Janik, H. Bacterial cellulose in the field of wound healing and regenerative medicine of skin: Recent trends and future prospectives. Polym. Bull. 2015, 72, 2399–2419. [Google Scholar] [CrossRef]
- He, W.; Wu, J.; Xu, J.; Mosselhy, D.A.; Zheng, Y.; Yang, S. Bacterial Cellulose: Functional Modification and Wound Healing Applications. Adv. Wound Care 2021, 10, 623–640. [Google Scholar] [CrossRef]
- Portela, R.; Leal, C.R.; Almeida, P.L.; Sobral, R.G. Bacterial cellulose: A versatile biopolymer for wound dressing applications. Microb. Biotechnol. 2019, 12, 586–610. [Google Scholar] [CrossRef]
- Zhong, C. Industrial-Scale Production and Applications of Bacterial Cellulose. Front. Bioeng. Biotechnol. 2020, 8, 605374. [Google Scholar] [CrossRef]
- Horue, M.; Silva, J.M.; Berti, I.R.; Brandão, L.R.; Barud, H.d.S.; Castro, G.R. Bacterial Cellulose-Based Materials as Dressings for Wound Healing. Pharmaceutics 2023, 15, 424. [Google Scholar] [CrossRef] [PubMed]
- Dang, R.; Xu, J.; Zhang, B.; Zhao, S.; Dang, Y. Preparation of bacterial cellulose-based antimicrobial materials and their applications in wound dressing: A review. Mater. Des. 2025; in press. [Google Scholar] [CrossRef]
- Pasaribu, K.M.; Mahendra, I.P.; Karina, M.; Masruchin, N.; Sholeha, N.A.; Gea, S.; Gupta, A.; Johnston, B.; Radecka, I. A review: Current trends and future perspectives of bacterial nanocellulose-based wound dressings. Int. J. Biol. Macromol. 2024, 279, 135602. [Google Scholar] [CrossRef]
- Sulaeva, I.; Hettegger, H.; Bergen, A.; Rohrer, C.; Kostic, M.; Konnerth, J.; Rosenau, T.; Potthast, A. Fabrication of bacterial cellulose-based wound dressings with improved performance by impregnation with alginate. Mater. Sci. Eng. C 2020, 110, 110619. [Google Scholar] [CrossRef]
- Zeng, A.; Yang, R.; Tong, Y.; Zhao, W. Functional bacterial cellulose nanofibrils with silver nanoparticles and its antibacterial application. Int. J. Biol. Macromol. 2023, 235, 123739. [Google Scholar] [CrossRef] [PubMed]
- Zhang, M.; Zhang, C.; Zhai, X.; Luo, F.; Du, Y.; Yan, C. Antibacterial mechanism and activity of cerium oxide nanoparticles. Sci. China Mater. 2019, 62, 1727–1739. [Google Scholar] [CrossRef]
- Younis, A.; Chu, D.; Li, S.; Younis, A.; Chu, D.; Li, S. Cerium Oxide Nanostructures and their Applications. In Functionalized Nanomaterials; IntechOpen: London, UK, 2016. [Google Scholar] [CrossRef]
- Panda, P.K.; Dash, P.; Yang, J.-M.; Chang, Y.-H. Development of chitosan, graphene oxide, and cerium oxide composite blended films: Structural, physical, and functional properties. Cellulose 2022, 29, 2399–2411. [Google Scholar] [CrossRef]
- Gofman, I.V.; Nikolaeva, A.L.; Khripunov, A.K.; Ivan’kova, E.M.; Shabunin, A.S.; Yakimansky, A.V.; Romanov, D.P.; Popov, A.L.; Ermakov, A.M.; Solomevich, S.O.; et al. Bacterial Cellulose-Based Nanocomposites Containing Ceria and Their Use in the Process of Stem Cell Proliferation. Polymers 2021, 13, 1999. [Google Scholar] [CrossRef]
- Petrova, V.A.; Gofman, I.V.; Dubashynskaya, N.V.; Golovkin, A.S.; Mishanin, A.I.; Ivan’kova, E.M.; Romanov, D.P.; Khripunov, A.K.; Vlasova, E.N.; Migunova, A.V.; et al. Chitosan Composites with Bacterial Cellulose Nanofibers Doped with Nanosized Cerium Oxide: Characterization and Cytocompatibility Evaluation. Int. J. Mol. Sci. 2023, 24, 5415. [Google Scholar] [CrossRef]
- Petrova, V.A.; Gofman, I.V.; Golovkin, A.S.; Mishanin, A.I.; Dubashynskaya, N.V.; Khripunov, A.K.; Ivan’kova, E.M.; Vlasova, E.N.; Nikolaeva, A.L.; Baranchikov, A.E.; et al. Bacterial Cellulose Composites with Polysaccharides Filled with Nanosized Cerium Oxide: Characterization and Cytocompatibility Assessment. Polymers 2022, 14, 5001. [Google Scholar] [CrossRef]
- Urbina, L.; Eceiza, A.; Gabilondo, N.; Corcuera, M.Á.; Retegi, A. Tailoring the in situ conformation of bacterial cellulose-graphene oxide spherical nanocarriers. Int. J. Biol. Macromol. 2020, 163, 1249–1260. [Google Scholar] [CrossRef]
- Mohamad, N.; Amin, M.C.I.M.; Pandey, M.; Ahmad, N.; Rajab, N.F. Bacterial cellulose/acrylic acid hydrogel synthesized via electron beam irradiation: Accelerated burn wound healing in an animal model. Carbohydr. Polym. 2014, 114, 312–320. [Google Scholar] [CrossRef] [PubMed]
- Nosrati, H.; Heydari, M.; Khodaei, M. Cerium oxide nanoparticles: Synthesis methods and applications in wound healing. Mater. Today Bio 2023, 23, 100823. [Google Scholar] [CrossRef]
- Pundir, S.; Priya, R.; Singh, K.; Kaur, H.; Choudhary, P. A systematic study on synthesis of CeO2 nanoparticles by various routes. IOP Conf. Ser. Earth Environ. Sci. 2023, 1110, 012030. [Google Scholar] [CrossRef]
- Patra, D.; El Kurdi, R. Curcumin as a novel reducing and stabilizing agent for the green synthesis of metallic nanoparticles. Green Chem. Lett. Rev. 2021, 14, 474–487. [Google Scholar] [CrossRef]
- Kalaycıoğlu, Z.; Geçim, B.; Erim, F.B. Green synthesis of cerium oxide nanoparticles from turmeric and kinds of honey: Characterisations, antioxidant and photocatalytic dye degradation activities. Adv. Nat. Sci. Nanosci. Nanotechnol. 2022, 13, 015016. [Google Scholar] [CrossRef]
- Deleanu, I.M.; Busuioc, C.; Deleanu, M.; Stoica-Guzun, A.; Rotaru, M.; Ștefan, V.A.; Isopencu, G. Antimicrobial Carboxymethyl Cellulose-Bacterial Cellulose Composites Loaded with Green Synthesized ZnO and Ag Nanoparticles for Food Packaging. Int. J. Mol. Sci. 2024, 25, 12890. [Google Scholar] [CrossRef]
- Isopencu, G.; Deleanu, I.; Busuioc, C.; Oprea, O.; Surdu, V.-A.; Bacalum, M.; Stoica, R.; Stoica-Guzun, A. Bacterial Cellulose—Carboxymethylcellulose Composite Loaded with Turmeric Extract for Antimicrobial Wound Dressing Applications. Int. J. Mol. Sci. 2023, 24, 1719. [Google Scholar] [CrossRef]
- Busuioc, C.; Isopencu, G.; Banciu, A.; Banciu, D.-D.; Oprea, O.; Mocanu, A.; Deleanu, I.; Zăuleţ, M.; Popescu, L.; Tănăsuică, R.; et al. Bacterial Cellulose Hybrid Composites with Calcium Phosphate for Bone Tissue Regeneration. Int. J. Mol. Sci. 2022, 23, 16180. [Google Scholar] [CrossRef]
- Orlando, I.; Basnett, P.; Nigmatullin, R.; Wang, W.; Knowles, J.C.; Roy, I. Chemical Modification of Bacterial Cellulose for the Development of an Antibacterial Wound Dressing. Front. Bioeng. Biotechnol. 2020, 8, 557885. [Google Scholar] [CrossRef]
- ISO 10993-5:2009(E); Biological Evaluation of Medical Devices—Part 5: Tests for In Vitro Cytotoxicity, Third Edit. ISO: Geneva, Switzerland, 2009.
- Braga, D.P.; Molina, D.O.G.; Pierre, B.; Daltro, P.B.; Daltro, G.D.C.; De Olyveira, G.M.; Basmaji, P.; Guastaldi, A.C. Hydrogel and bacterial cellulose mats behavior with calcium phosphate deposition. In Proceedings of the Front Bioeng Biotechnol Conference Abstract: 10th World Biomaterials Congress, Montréal, QC, Canada, 17–22 May 2016; Volume 4. [Google Scholar] [CrossRef]
- Farahmandjou, M.; Zarinkamar, M.; Firoozabadi, T.P.; Farahmandjou, M.; Zarinkamar, M.; Firoozabadi, T.P. Synthesis of Cerium Oxide (CeO2) nanoparticles using simple CO-precipitation method. Rev. Mex. Física 2016, 62, 496–499. [Google Scholar]
- Prabaharan, D.M.D.M.; Sadaiyandi, K.; Mahendran, M.; Sagadevan, S. Structural, Optical, Morphological and Dielectric Properties of Cerium Oxide Nanoparticles. Mater. Res. 2016, 19, 478–482. [Google Scholar] [CrossRef]
- Stanescu, P.-O.; Radu, I.-C.; Alexa, R.L.; Hudita, A.; Tanasa, E.; Ghitman, J.; Stoian, O.; Tsatsakis, A.; Ginghina, O.; Zaharia, C.; et al. Novel chitosan and bacterial cellulose biocomposites tailored with polymeric nanoparticles for modern wound dressing development. Drug Deliv. 2021, 28, 1932–1950. [Google Scholar] [CrossRef] [PubMed]
- Putri, G.E.; Arifani, N.; Wendari, T.P.; Syafri, E.; Ilyas, R.; Labanni, A.; Arief, S. Nanocomposites of cellulose-modified cerium oxide nanoparticles and their potential biomedical applications. Case Stud. Chem. Environ. Eng. 2024, 10, 101013. [Google Scholar] [CrossRef]
- Chowdhuri, A.R.; Tripathy, S.; Haldar, C.; Chandra, S.; Das, B.; Roy, S.; Sahu, S.K. Theoretical and experimental study of folic acid conjugated silver nanoparticles through electrostatic interaction for enhance antibacterial activity. RSC Adv. 2015, 5, 21515–21524. [Google Scholar] [CrossRef]
- Elamawi, R.M.; Al-Harbi, R.E.; Hendi, A.A. Biosynthesis and characterization of silver nanoparticles using Trichoderma longibrachiatum and their effect on phytopathogenic fungi. Egypt. J. Biol. Pest Control 2018, 28, 28. [Google Scholar] [CrossRef]
- Dong, Y.; Zhu, H.; Shen, Y.; Zhang, W.; Zhang, L. Antibacterial activity of silver nanoparticles of different particle size against Vibrio Natriegens. PLoS ONE 2019, 14, e0222322. [Google Scholar] [CrossRef]
- Chen, H.-I.; Chang, H.-Y. Synthesis of nanocrystalline cerium oxide particles by the precipitation method. Ceram. Int. 2005, 31, 795–802. [Google Scholar] [CrossRef]
- Pop, O.L.; Mesaros, A.; Vodnar, D.C.; Suharoschi, R.; Tăbăran, F.; Magerușan, L.; Tódor, I.S.; Diaconeasa, Z.; Balint, A.; Ciontea, L.; et al. Cerium Oxide Nanoparticles and Their Efficient Antibacterial Application In Vitro against Gram-Positive and Gram-Negative Pathogens. Nanomaterials 2020, 10, 1614. [Google Scholar] [CrossRef]
- Cui, Z.; Zhang, L.; Xue, Y.; Feng, Y.; Wang, M.; Chen, J.; Ji, B.; Wang, C.; Xue, Y. Effects of shape and particle size on the photocatalytic kinetics and mechanism of nano-CeO2. Int. J. Miner. Met. Mater. 2022, 29, 2221–2231. [Google Scholar] [CrossRef]
- Asif, M.; Yasmin, R.; Asif, R.; Ambreen, A.; Mustafa, M.; Umbreen, S. Green Synthesis of Silver Nanoparticles (AgNPs), Structural Characterization, and their Antibacterial Potential. Dose-Response 2022, 20, 15593258221088709. [Google Scholar] [CrossRef]
- Oraby, M.; Ahmed, A.S.; Abdel-Lateef, M.A.; Mostafa, M.A.; Hassan, A.I. Employ FTIR spectroscopic method for determination of certain multiple sclerosis medications in plasma and pharmaceutical formulations. Microchem. J. 2021, 167, 106329. [Google Scholar] [CrossRef]
- Venditti, I.; Fontana, L.; Fratoddi, I.; Battocchio, C.; Cametti, C.; Sennato, S.; Mura, F.; Sciubba, F.; Delfini, M.; Russo, M.V. Direct interaction of hydrophilic gold nanoparticles with dexamethasone drug: Loading and release study. J. Colloid Interface Sci. 2014, 418, 52–60. [Google Scholar] [CrossRef] [PubMed]
- Farias, I.A.P.; dos Santos, C.C.L.; Sampaio, F.C. Antimicrobial Activity of Cerium Oxide Nanoparticles on Opportunistic Microorganisms: A Systematic Review. BioMed Res. Int. 2018, 2018, e1923606. [Google Scholar] [CrossRef] [PubMed]
- Loo, Y.Y.; Rukayadi, Y.; Nor-Khaizura, M.-A.; Kuan, C.H.; Chieng, B.W.; Nishibuchi, M.; Radu, S. In Vitro Antimicrobial Activity of Green Synthesized Silver Nanoparticles Against Selected Gram-negative Foodborne Pathogens. Front. Microbiol. 2018, 9, 1555. [Google Scholar] [CrossRef]
- Mikhailova, E.O. Silver Nanoparticles: Mechanism of Action and Probable Bio-Application. J. Funct. Biomater. 2020, 11, 84. [Google Scholar] [CrossRef]
- Chen, S.; Wang, Y.; Bao, S.; Yao, L.; Fu, X.; Yu, Y.; Lyu, H.; Pang, H.; Guo, S.; Zhang, H.; et al. Cerium oxide nanoparticles in wound care: A review of mechanisms and therapeutic applications. Front. Bioeng. Biotechnol. 2024, 12, 1404651. [Google Scholar] [CrossRef]
- Gobi, R.; Babu, R.S.; Rani, M.U.; Gothandam, K.M.; Prakash, J.; Venkatasubbu, G.D. Investigating the effect of antibacterial cerium oxide nanoparticles embedded in biodegradable PVA/chitosan films for wound healing application: An in-vitro study. Emergent. Mater. 2024, 1–21. [Google Scholar] [CrossRef]
- Elabbasy, M.T.; Samak, M.A.; Saleh, A.A.; El-Shetry, E.S.; Almalki, A.; El-Morsy, M.; Menazea, A. Enhancement of wound dressings through cerium canadate and hydroxyapatite-infused hyaluronic acide and PVA membranes: A comprehensive characterization and biocompatibility study. Mater. Chem. Phys. 2024, 328, 129972. [Google Scholar] [CrossRef]

| Sample Code | Precursor | Precipitating Agent |
|---|---|---|
| BC-CeO2-TE | (NH4)2[Ce(NO3)6] | 50 mL TE |
| BC-CeO2-TE-OH | 50 mL TE + 10 mL NH4OH | |
| BC-CeO2-OH | 10 mL NH4OH | |
| BC-Ag-OH | AgNO3 | 10 mL NH4OH |
| Sample Code | Organic Component (%) | Residue (%) |
|---|---|---|
| BC | 99.7 | 0.3 |
| BC-CeO2-TE | 69.4 | 30.6 |
| BC-CeO2-TE-OH | 65.8 | 34.2 |
| BC-CeO2-OH | 55.5 | 44.5 |
| BC-Ag-OH | 96.1 | 3.9 |
| Sample Code | C (wt%) | Ce (wt%) | O (wt%) |
|---|---|---|---|
| BC-CeO2-TE | 7.5 | 59.4 | 33.1 |
| BC-CeO2-TE-OH | 27.6 | 53.0 | 19.4 |
| BC-CeO2-OH | 29.0 | 47.3 | 23.7 |
Disclaimer/Publisher’s Note: The statements, opinions and data contained in all publications are solely those of the individual author(s) and contributor(s) and not of MDPI and/or the editor(s). MDPI and/or the editor(s) disclaim responsibility for any injury to people or property resulting from any ideas, methods, instructions or products referred to in the content. |
© 2025 by the authors. Licensee MDPI, Basel, Switzerland. This article is an open access article distributed under the terms and conditions of the Creative Commons Attribution (CC BY) license (https://creativecommons.org/licenses/by/4.0/).
Share and Cite
Dogaru, A.-I.; Oprea, O.-C.; Isopencu, G.-O.; Banciu, A.; Jinga, S.-I.; Busuioc, C. Bacterial Cellulose-Based Nanocomposites for Wound Healing Applications. Polymers 2025, 17, 1225. https://doi.org/10.3390/polym17091225
Dogaru A-I, Oprea O-C, Isopencu G-O, Banciu A, Jinga S-I, Busuioc C. Bacterial Cellulose-Based Nanocomposites for Wound Healing Applications. Polymers. 2025; 17(9):1225. https://doi.org/10.3390/polym17091225
Chicago/Turabian StyleDogaru, Alexandra-Ionela, Ovidiu-Cristian Oprea, Gabriela-Olimpia Isopencu, Adela Banciu, Sorin-Ion Jinga, and Cristina Busuioc. 2025. "Bacterial Cellulose-Based Nanocomposites for Wound Healing Applications" Polymers 17, no. 9: 1225. https://doi.org/10.3390/polym17091225
APA StyleDogaru, A.-I., Oprea, O.-C., Isopencu, G.-O., Banciu, A., Jinga, S.-I., & Busuioc, C. (2025). Bacterial Cellulose-Based Nanocomposites for Wound Healing Applications. Polymers, 17(9), 1225. https://doi.org/10.3390/polym17091225

